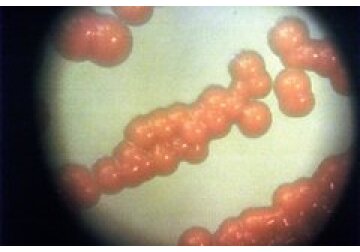

Раскрыт настоящий источник глобальных выбросов метана
PNAS: рост глобальных выбросов метана связали с микробами
Ученые Калифорнийского университета в Боулдере раскрыли настоящий источник роста глобальных выбросов метана, который, как оказалось, был вызван деятельностью микробов, а не сжиганием ископаемого топлива. Об этом сообщается в статье, опубликованной в журнале Proceedings of the National Academy of Sciences (PNAS).
Метан — мощный парниковый газ, который задерживает значительно больше тепла, чем углекислый газ. Ранее считалось, что наибольший вклад в выбросы метана вносит добыча ископаемого топлива, однако новое исследование показало, что основными источниками стали микробные процессы, связанные с разложением органического материала в таких средах, как болота и сельскохозяйственные угодья.
Ученые проанализировали изотопный состав метана, собранного в разных точках мира. Они сосредоточились на соотношении углерода-13 в образцах, которое позволяет отличить метан микробного происхождения от метана, возникающего при сжигании ископаемого топлива. Лаборатория глобального мониторинга NOAA предоставила данные с 22 мест, собираемых с 1998 года.
Результаты анализа показали, что с 2020 по 2022 годы до 90 процента роста концентрации метана в атмосфере связано с микробными источниками. Это особенно заметно на фоне резкого увеличения выбросов, наблюдаемого с 2007 года. Однако команда не смогла определить, являются ли эти выбросы следствием природных процессов в водно-болотных угодьях или антропогенной деятельностью.
Предыдущее исследование выбросов метана не учитывало изотопные данные, что могло привести к искажению выводов. Новое исследование, напротив, показало, что микробные процессы стали ведущей причиной увеличения выбросов, несмотря на значительные объемы метана, производимого ископаемым топливом.
Исследователи подчеркивают необходимость продолжения работы по точному определению источников микробных выбросов. По мере того как планета нагревается, метановые выбросы могут увеличиваться, и, хотя борьба с метаном важна, основное внимание должно быть уделено сокращению выбросов углекислого газа для долгосрочного решения климатического кризиса.
PNAS